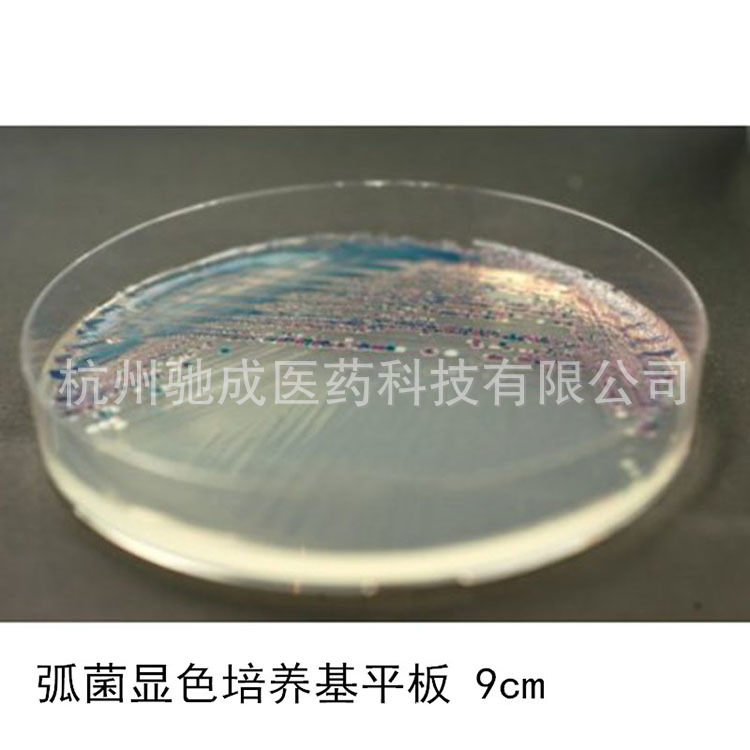

1688工业品为您提供在线免费查询更多化学试剂详细参数、实时报价、规格一览表。更多关于化学试剂多少钱一瓶/化学试剂报价明细/化学试剂规格型号价格表/化学试剂批发市场价格/化学试剂官方报价等咨询,尽在1688工业品。询底价>
为你找到生化试剂相关产品

红细胞裂解液(RBC Lysis Buffer,10×)
上海
在线询价

重楼皂苷II/50773-42-7/源叶 B21669/Polyphyllin II/HPLC≥98%
上海
在线询价

029110环凯无菌液体石蜡 10ml/支覆盖液体培养基用于厌氧培养试剂
广东广州
在线询价

莫匹罗星锂盐(5mg/支)HB0384-6a青岛海博培养基
山东青岛
在线询价

硬脂酸钠分析纯 AR 250g/瓶 CAS:822-16-2
山东青岛
在线询价

P9240 马铃薯葡萄糖肉汤(PDB)用于酵母菌及霉菌的增菌培养
北京
在线询价
科玛嘉 弧菌显色平板 9cm 即用型平皿 用于弧菌的选择分类培养
浙江杭州
在线询价

TBD TBD21HY 优级胎牛血清,100ml/瓶
北京
在线询价

CM163 乙基紫叠氮钠肉汤培养基 北京陆桥
广东东莞
在线询价

乙酰辅酶A / 乙酰辅酶A钠盐 ≥93%HPLC 科研实验试剂102029-73-2
安徽合肥
在线询价

90mm甘露醇卵黄多粘菌素(MYP)琼脂<蜡样芽孢杆菌检验>
江苏南京
在线询价

90mm滤膜肠球菌琼脂培养基<肠球菌、 链球菌检验系列> 厂家直销
安徽马鞍山
在线询价
查看更多产品及报价
100+生化试剂相关产品等你解锁
在线寻源3000行家正在找货
免费询价,源头正品,上1688工业品,全国的工业正品交易平台





